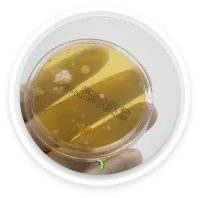
MONITORAMENTO AMBIENTAL

TSA (Tryptic Soy Agar / Ágar Triptona de Soja) é um meio de cultura não seletivo e não diferencial, usado para crescimento de uma grande variedade de bactérias e fungos.
Serve como base para meios enriquecidos (ex: ágar sangue, ágar chocolate).
É indicado para monitoramento ambiental em ambientes controlados, além de testes de contagem microbiana (TAMC).
Triptona (digestão de caseína): 15 g
Peptona de soja: 5 g
Cloreto de sódio: 5 g
Ágar: 15 g
pH final: 7,3 ± 0,2 (a 25 °C).
Aspecto pó: bege claro, higroscópico.
Aspecto preparado: âmbar claro, ligeiramente opaco.
Validade: normalmente 12 a 24 meses (dependendo do fabricante e lote).
Armazenamento:
Pó: 10–30 °C, em local seco.
Placas prontas: 2–8 °C, seladas até o uso.
Controle de qualidade (exemplo de microrganismos testados):
E. coli ATCC 25922 — crescimento satisfatório.
S. aureus ATCC 25923 — crescimento satisfatório.
Candida albicans ATCC 10231 — crescimento satisfatório.
Aspergillus brasiliensis ATCC 16404 — crescimento satisfatório.
WhatsApp us